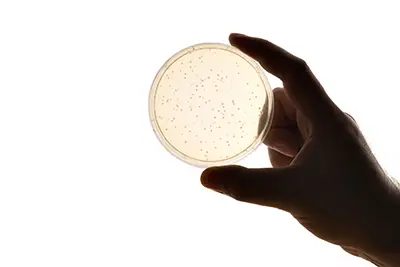

The Chill Factor
For thirty years, the results of scientific studies on the conservation of probiotic strains have underscored the obvious: Refrigeration is a key factor for the survival for these friendly—and fragile—bacteria.[1] While some probiotic strains are relatively stronger than others (Bifidobacteria are even less resistant than Lactobacilli), the fact remains that sensitivity to temperature and humidity is a constant concern for the durability of probiotics.[2], [3] Another sine qua non condition for the survival of probiotics is protection against gastric acidity.[4] But let’s focus here on the issue of refrigeration. To simply illustrate this issue, here are some study conclusions validating the importance of probiotic refrigeration.
Bifidobacteria
Bifidobacteria are very sensitive to temperature, as a study validated by showing a significantly higher mortality of Bifidobacterium longum during storage at 20 °C (room temperature), compared to storage at 4 °C.[5] Along the same lines, another study showed that the vitality of Bifidobacteria is inversely proportional to storage temperature: at 15 °C and 25 °C, a significative decline was observed for all Bifidobacterium species analyzed.[6] In a third study, microbial survival was found to be better at lower storage temperature, especially for Bifidobacterium bifidum.[7] Finally, a fourth study concluded by explaining that higher temperature conditions induced greater mortality of Bifidobacteria.[8]
Lactobacilli
According to a study, the survival of L. paracasei NFBC 338 and L. salivarius UCC 118 strains during storage was inversely proportional to storage temperature, being as low as 11% and 2%, respectively, after two months of storage at 15 °C.[9] Another study, done on Lactobacillus delbrueckii spp. bulgaricus, showed high mortality rates at room temperature, while at 4 °C, survival was higher.[10]
New Roots Herbal’s Refrigerated Probiotics v. Competitor’s Unrefrigerated Probiotics
New Roots Herbal’s Refrigerated Probiotics v. Competitor’s Unrefrigerated Probiotics
Recently, New Roots Herbal commissioned an ISO 17025–accredited analytical laboratory to perform a stability comparison between a refrigerated product from its probiotics line and a competing nonrefrigerated product. Both products had identical expiration dates, and a remaining conservation duration of 18 months. Knowing that Health Canada labeling allows 24 months for preservation duration on probiotics, six months had therefore elapsed since their manufacture. On the first day of the test, the unrefrigerated competitor’s probiotic already contained only 73% of the amount of colony-forming units (CFUs) claimed on the label; after 60 days (i.e. 16 months before its expiration date) at room temperature between 19 °C and 25 °C, the amount had fallen to only 40% of alleged CFUs. In comparison, after 60 days of storage in a refrigerator at a temperature between 2 °C and 8 °C, New Roots Herbal’s product still contained 110% of the declared number of UFC on the label.[11]
 The Brief on Effective Probiotics
The Brief on Effective Probiotics
So, next time you visit to a health-food store, rather than ask the question “to be or not to be refrigerated?” simply ask: “Where is the fridge?”
Another critical factor for choosing effective probiotics is their delivery. Join us next issue for a complete review showing how enteric-coating capsules protect probiotic strains from strong gastric acid.

[1] Abd El Gawad, I.A., M.M. Metwally, S.A. El Nockrashy, and K.E. Ahmed. “Spray drying of lactic acid cultures. II. The effect of culture conditions and storage on microorganisms survival.” Egyptian Journal of Dairy Science, Vol. 17 (1989): 273–281.
[2] Kailasapathy, K., and J. Chin. “Survival and therapeutic potential of probiotic organisms with reference to Lactobacillus acidophilus and Bifidobacterium spp.” Immunology and Cell Biology, Vol. 78, No. 1 (2000): 80–88.
[3] Arepally, D., R.S. Reddy, and T.K. Goswami. “Studies on survivability, storage stability of encapsulated spray dried probiotic powder.” Current Research in Food Science, Vol. 3 (2020): 235–242.
[4] Millette, M., A. Nguyen, K.M. Amine, and M. Lacroix. “Gastrointestinal survival of bacteria in commercial probiotic products.” International Journal of Probiotics and Prebiotics, Vol. 8, No. 4 (2013): 149–156.
[5] Bruno, F.A., and N.P. Shah. “Viability of two freeze-dried strains of Bifidobacterium and of commercial preparations at various temperatures during prolonged storage.” Journal of Food Science, Vol. 68, No. 7 (2003): 2336–2339.
[6] Simpson, P.J., C. Stanton, G.F. Fitzgerald, and R.P. Ross. “Intrinsic tolerance of Bifidobacterium species to heat and oxygen and survival following spray drying and storage.” Journal of Applied Microbiology, Vol. 99, No. 3 (2005): 493–501.
[7] Wirjantoro, T.I., and A. Phianmongkhol. “The viability of lactic acid bacteria and Bifidobacterium bifidum in yoghurt powder during storage.” Chiang Mai University Journal of Natural Sciences, Vol. 8, No. 1 (2009): 95–104.
[8] Abe, F., H. Miyauchi, A. Uchijima, T. Yaeshima, and K. Iwatsuki. “Effects of storage temperature and water activity on the survival of bifidobacteria in powder form.” International Journal of Dairy Technology, Vol. 62, No. 2 (2009): 234–239.
[9] Gardiner, G.E., E. O’Sullivan, J. Kelly, M.A. Auty, G.F. Fitzgerald, J.K. Collins, R.P. Ross, and C. Stanton. “Comparative survival rates of human-derived probiotic Lactobacillus paracasei and L. salivarius strains during heat treatment and spray drying.” Applied and Environmental Microbiology, Vol. 66, No. 6 (2000): 2605–2612.
[10] Teixeira, P., M.H. Castro, F.X. Malcata, and R.M. Kirby. “Survival of Lactobacillus delbruekii spp. bulgaricus following spray-drying.” Journal of Dairy Science, Vol. 78, No. 5 (1995): 1025–1031.
[11] New Roots Herbal archive data available upon request.

